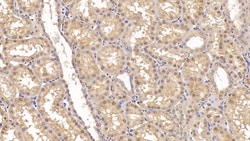
Invitrogen ACVR2A Monoclonal Antibody (C1), Invitrogen 20 &mu;L; Unconjugated:Antibodies,
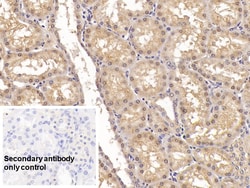
Invitrogen ACVR2A Monoclonal Antibody (C1), Invitrogen 20 &mu;L; Unconjugated:Antibodies,

missing translation for 'onlineSavingsMsg'
Learn More
Learn More
Invitrogen™ ACVR2A Monoclonal Antibody (C1), Invitrogen™
Mouse Monoclonal Antibody
Brand: Invitrogen™ MA551172
This item is not returnable.
View return policy
Description
Activin A receptor kinase (ACVR2A) is a type II member of the TGF-beta family of receptor Serine/Threonine kinases. ACVR2A is involved in the activin and myostatin signaling pathway. (ACVR2A Aliases: ACVR2, ACTRII). These receptors are all transmembrane proteins, composed of a ligand-binding extracellular domain with cysteine-rich region, a transmembrane domain, and a cytoplasmic domain with predicted serine/threonine specificity. Type I receptors are essential for signaling, and type II receptors are required for binding ligands and for expression of type I receptors. Type I and II receptors form a stable complex after ligand binding, resulting in phosphorylation of type I receptors by type II receptors. Type II receptors are considered to be constitutively active kinases.
Specifications
| ACVR2A | |
| Monoclonal | |
| 1 mg/mL | |
| PBS with 50% glycerol and 0.05% Proclin 300; pH 7.4 | |
| P27037 | |
| ACVR2A | |
| Recombinant Human ACVR2A protein, Ala20-Pro135 (Accession #P27037). | |
| 20 μL | |
| Primary | |
| Human, Pig | |
| Antibody | |
| IgG2b κ |
| Immunohistochemistry (Paraffin), Western Blot | |
| C1 | |
| Unconjugated | |
| ACVR2A | |
| activin A receptor type 2A; activin A receptor type IIA; activin A receptor, type IIA; activin receptor IIA; activin receptor type IIA; Activin receptor type-2A; Actrii; ActrIIa; ACTR-IIA; ACVR2; Acvr2a; rActR-II; TactrII; type II activin receptor | |
| Mouse | |
| Protein A/G | |
| RUO | |
| 397282, 92 | |
| Store at 4°C short term. For long term storage, store at -20°C, avoiding freeze/thaw cycles. | |
| Liquid |
Product Content Correction
Your input is important to us. Please complete this form to provide feedback related to the content on this product.
Product Title
Spot an opportunity for improvement?Share a Content Correction